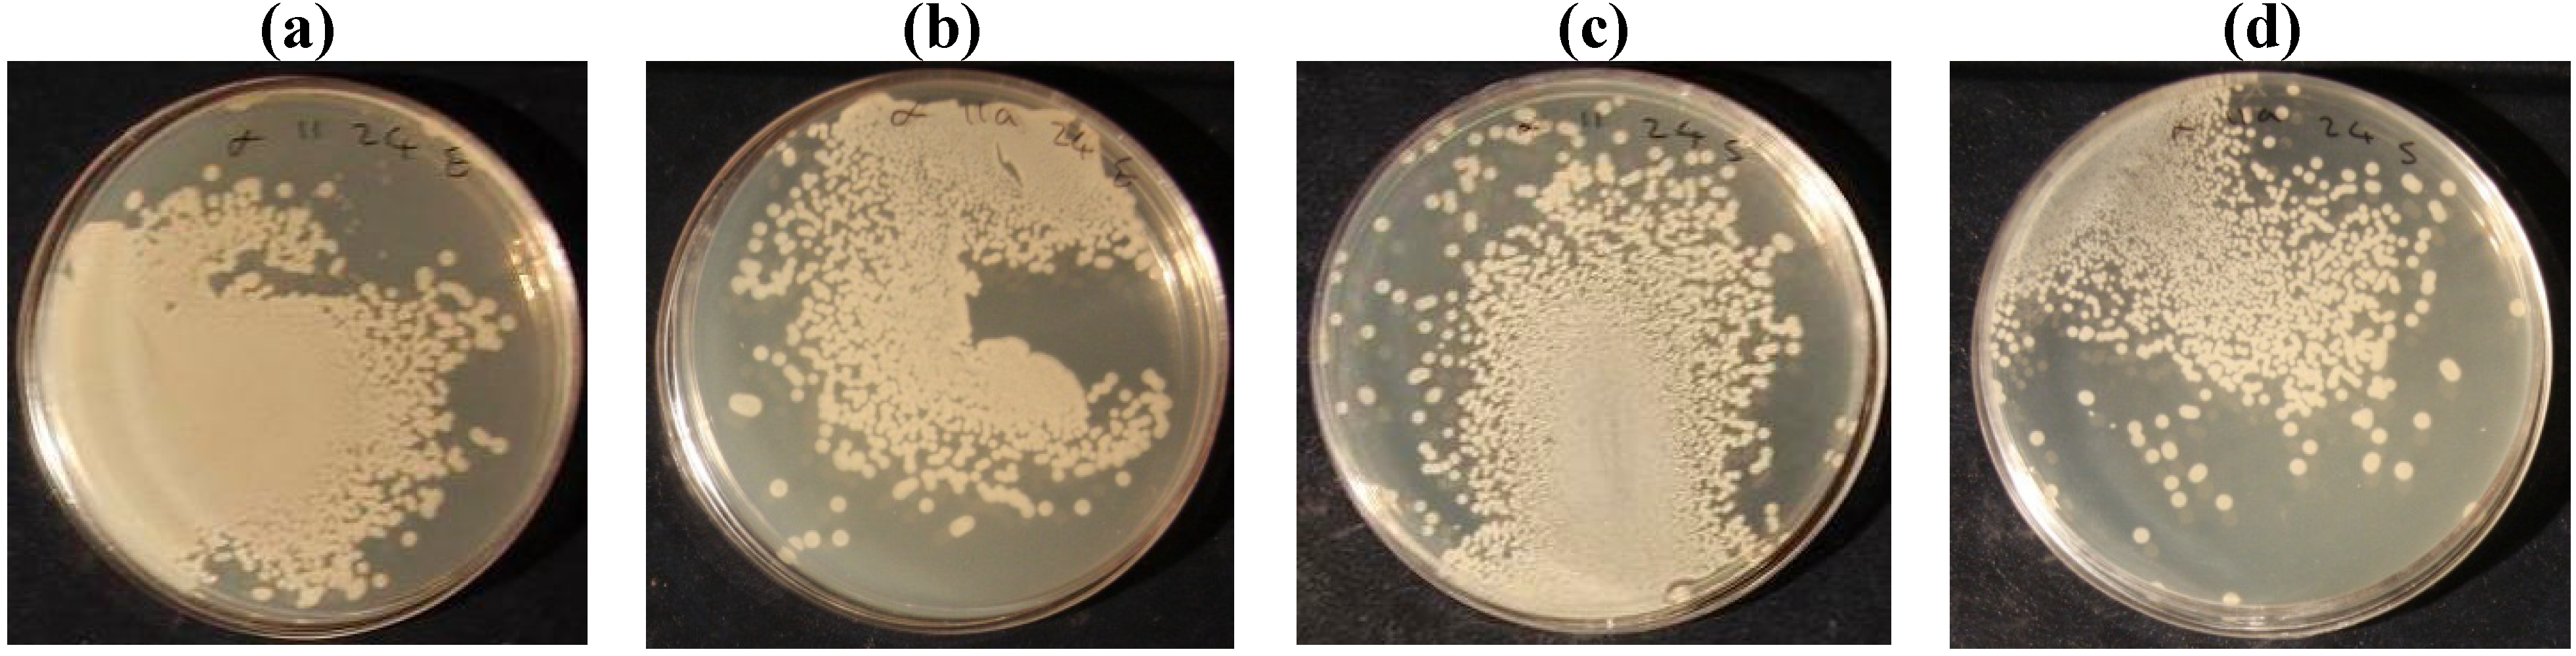

Laser Treatment of Cotton Fabric for Durable Antibacterial Properties of Silver Nanoparticles
Abstract
:1. Introduction
2. Results and Discussion
| Power (w) | 100 | 75 | 50 | Untreated | ||
|---|---|---|---|---|---|---|
| Scan speed (cm/s) | 1000 | 2000 | 1000 | 2000 | 1000 | |
| L* | 69.05 | 69.87 | 70.16 | 70.11 | 70.41 | 70.45 |
| A* | −5.49 | −5.53 | −2.76 | −4.58 | −2.13 | −2.38 |
| B* | −18.41 | −18.18 | −12.36 | −7.45 | −14.75 | −16.09 |
| K/S | 0.832 | 0.782 | 0.731 | 0.651 | 0.648 | 0.636 |
| ∆ E | 4.12 | 3.82 | 3.76 | 2.6 | 1.36 | – |

| Bacteria | Laser power (w) | 100 | 75 | 50 | Untreated | ||
|---|---|---|---|---|---|---|---|
| Scan speed (cm/s) | 1000 | 2000 | 1000 | 2000 | 1000 | ||
| Escherichia Coli | Before laundering | 99.25 | 98.65 | 98.4 | 96.45 | 98.05 | 39.9 |
| After laundering | 98.3 | 97.45 | 96.35 | 96.05 | 96.1 | 26.2 | |
| staphylococcus aureus | Before laundering | 97.1 | 91.25 | 82.5 | 77.5 | 69.65 | 37.5 |
| After laundering | 87 | 80.25 | 73.6 | 68.25 | 45 | 23.3 | |
| (%) Ag content (EDAX analysis) | 5.25 | 5.03 | 4.82 | 4.67 | 4.61 | 4.34 | |
| Carboxyl groups content (meq/100g) | 3.86 | 3.24 | 3.12 | 2.87 | 2.08 | 1.36 | |

3. Experimental Section
3.1. Materials
3.2. Methods
4. Conclusions
References
- Schindler, W.D.; Hauser, P.J. Chemical Finishing of Textiles; Woodhead Publishing Limited: Cambridge, UK, 2004. [Google Scholar]
- Derek, H. Textile Finishing; Society of Dyers & Colourists: West Yorkshire, UK, 2003. [Google Scholar]
- Ilic, V.; Saponjic, Z.; Vodnik, V.; Potkonjak, B.; Jovancic, P.; Nedeljkovic, J.; Radetic, M. The influence of silver content on antimicrobial activity and color of cotton fabrics functionalized with Ag nanoparticles. Carbohydr. Polym. 2009, 78, 564–569. [Google Scholar] [CrossRef]
- Gao, Y.; Cranston, R. Recent advances in antimicrobial treatments of textiles. Text. Res. J. 2008, 78, 60–72. [Google Scholar] [CrossRef]
- Zhang, F.; Wu, X.; Chen, Y.; Lin, H. Application of silver nanoparticles to cotton fabric as an antibacterial textile finish. Fiber. Polym. 2009, 10, 496–501. [Google Scholar] [CrossRef]
- Lee, H.J.; Yeo, S.Y.; Jeong, S.H. Antibacterial effect of nanosized silver colloidal solution on textile fabrics. J. Mater. Sci. 2003, 38, 2199–2204. [Google Scholar] [CrossRef]
- Purwar, R.; Joshi, M. Recent developments in antimicrobial finishing of textiles: A review. AATCC Rev. 2004, 4, 22–26. [Google Scholar]
- Rai, M.; Yadav, A.; Gade, A. Recent developments in antimicrobial finishing of textiles. Biotechnol. Adv. 2009, 27, 76–83. [Google Scholar] [CrossRef] [PubMed]
- Tanner, B.D. Antimicrobial fabrics-Issued and opportunities in the era of antibiotic resistance (in Chinese). China Fiber Insp. 2009, 2, 30–33. [Google Scholar]
- Carneiro, N.; Souto, A.P. Dyeability of corona-treated fabrics. Color. Technol. 2001, 117, 298–302. [Google Scholar] [CrossRef]
- Agostino, R. Plasma Processing of Polymers; Kluwer Academic: Norwell, MA, USA, 1997; pp. 348–350. [Google Scholar]
- Malek, R.M.A.; Holme, I. The effect of plasma treatment on some properties of cotton. Iran. Polym. J. 2003, 12, 271–280. [Google Scholar]
- Wakida, T.; Takeda, K. Free radicals in cellulose fibers treated with low temperature plasma. Text. Res. J. 1989, 59, 49–53. [Google Scholar] [CrossRef]
- Ferrero, F.; Bongiovanni, R. Improving the surface properties of cellophane by air plasma treatment. Surf. Coat. Technol. 2006, 200, 4770–4776. [Google Scholar] [CrossRef]
- Rouette, H.K. Encyclopedia of Textile Finishing; Springer: Berlin, Germany, 2001. [Google Scholar]
- Dascalu, T.; Acosta-Ortiz, S.; Ortiz-Morales, M.; Compean, I. Removal of the indigo color by laser beam-denim interaction. Opt. Laser Eng. 2002, 34, 179–189. [Google Scholar]
- Ortiz-Morales, M.; Poterasu, M.; Acosta-Ortiz, S.; Compean, I.; Hernandez-Alvardo, M.R. A comparison between characteristics of various laser-based denim fading processes. Opt. Lasers Eng. 2003, 39, 15–24. [Google Scholar] [CrossRef]
- Knittel, D.; Schollmeyer, E. Surface structuring of synthetic fibres by UV laser. Polym. Int. 1998, 45, 110–115. [Google Scholar] [CrossRef]
- Nourbakhsh, S.; Ebrahimi, I.; Valipour, P. Laser treatment of wool fabric for felting shrinkage control. Fiber. Polym. 2011, 12, 521–527. [Google Scholar] [CrossRef]
- Kostic, M.; Radic, N.; Obradovic, B.M.; Dimitrijevic, S.; Kuraica, M.M.; Skundric, P. Silver-loaded cotton/polyester fabric modified by dielectric barrier discharge treatment. Plasma Process. Polym. 2009, 6, 58–67. [Google Scholar] [CrossRef]
- Lee, H.J.; Yeo, S.Y.; Jeong, S.H. Antibacterial effect of nanosized silver colloidal solution on textile fabrics. J. Mater. Sci. 2009, 38, 2199–2204. [Google Scholar] [CrossRef]
- Shahidi, S.; Rashidi, A.; Ghoranneviss, M.; Anvari, A.; Rahimi, M.K.; Bameni Moghaddam, M.; Wiener, J. Investigation of metal absorption and antibacterial activity on cotton fabric modified by low temperature plasma. Cellulose 2010, 17, 627–634. [Google Scholar] [CrossRef]
- Yuranova, T.; Rincon, A.G.; Bozzi, A.; Parra, S.; Pulgarin, C.; Albers, P.; Kiwi, J. Antibacterial textiles prepared by RF-plasma and vacuum-UV mediated deposition of silver. J. Photochem. Photobiol. A Chem. 2003, 161, 27–34. [Google Scholar] [CrossRef]
- Shateri Khalil-Abad, M.; Yazdanshenas, M.E.; Nateghi, M.R. Effect of cationization on adsorption of silver nanoparticles on cotton surfaces and its antibacterial activity. Cellulose 2009, 16, 1147–1157. [Google Scholar] [CrossRef]
- El-Shishtawy, R.M.; Asiri, A.M.; Abdelwahed, N.A.M.; Al-Otaibi, M.M. In situ production of silver nanoparticle on cotton fabric and its antimicrobial evaluation. Cellulose 2011, 18, 75–82. [Google Scholar] [CrossRef]
- Collier, B.J.; Epps, H.H. Textile Testing and Analysis; Prentice Hall: Upper Saddle River, NJ, USA, 1999; pp. 209–211. [Google Scholar]
- Vaideki, K.; Jayakumar, S.; Thilagavathi, G.; Rajendran, R. A study on the antimicrobial efficacy of RF oxygen plasma and neem extract treated cotton fabrics. Appl. Surf. Sci. 2007, 253, 7323–7329. [Google Scholar] [CrossRef]
- Yang, C.Q.; Chen, D.; Guan, J.; He, Q. Cross-linking cotton cellulose by the combination of maleic acid and sodium hypophosphite 1. Fabric wrinkle resistant. Ind. Eng. Chem. Res. 2010, 49, 8325–8332. [Google Scholar] [CrossRef]
- American Association of Textile Chemists and Colorists (AATCC). AATCC Technical Manual 1997; AATCC: Research Triangle Park, NC, USA, 1996. [Google Scholar]
- Rezic, I.; Steffan, I. ICP-OES determination of metals present in textile materials. Microchem. J. 2007, 85, 46–51. [Google Scholar] [CrossRef]
- Tatro, M.E. Optical Emission Inductively Coupled Plasma in Environmental Analysis. Encyclopedia of Analytical Chemistry; Meyers, R.A., Ed.; John Wiley & Sons Ltd: Chichester, UK, 2001. [Google Scholar]
- Technical Association of the Pulp and Paper Industry (TAPPI). Carboxyl Content of Pulp, Test Method T 237 cm-98; TAPPI: Norcross, GA, USA, 1977. Available online: www.tappi.org/content/tag/sarg/t237.pdf (accessed on 4 June 2012).
© 2012 by the authors; licensee MDPI, Basel, Switzerland. This article is an open access article distributed under the terms and conditions of the Creative Commons Attribution license (http://creativecommons.org/licenses/by/3.0/).
Share and Cite
Nourbakhsh, S.; Ashjaran, A. Laser Treatment of Cotton Fabric for Durable Antibacterial Properties of Silver Nanoparticles. Materials 2012, 5, 1247-1257. https://doi.org/10.3390/ma5071247
Nourbakhsh S, Ashjaran A. Laser Treatment of Cotton Fabric for Durable Antibacterial Properties of Silver Nanoparticles. Materials. 2012; 5(7):1247-1257. https://doi.org/10.3390/ma5071247
Chicago/Turabian StyleNourbakhsh, Shirin, and Ali Ashjaran. 2012. "Laser Treatment of Cotton Fabric for Durable Antibacterial Properties of Silver Nanoparticles" Materials 5, no. 7: 1247-1257. https://doi.org/10.3390/ma5071247
APA StyleNourbakhsh, S., & Ashjaran, A. (2012). Laser Treatment of Cotton Fabric for Durable Antibacterial Properties of Silver Nanoparticles. Materials, 5(7), 1247-1257. https://doi.org/10.3390/ma5071247




